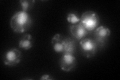
YLR059C
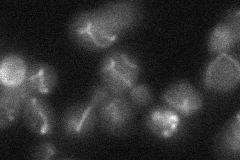
YLR059C
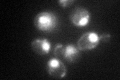
YLR059C

View description
3'-5' RNA exonuclease; involved in 3'-end processing of U4 and U5 snRNAs, 5S and 5.8S rRNAs, and RNase P and RNase MRP RNA; localized to mitochondria and null suppresses escape of mtDNA to nucleus in yme1 yme2 mutants; RNase D exonuclease
Localization:
Intensity:
Fold change:
Significance:
-
C’ GFP library in SD
nucleus:mitochondria82.9 -
N' NOP1pr-GFP in SD

mitochondria136.268 -
N' TEF2pr-mCherry in SD

missing0 -
N' NATIVEpr-GFP in SD
mitochondria18.7016 -
N' TEF2pr-VC and Cyto-VN in SD

#N/A0 -
C’ GFP library in SD+DTT

nucleus.mitochondria71.640.86No -
C’ GFP library in SD+H2O2
nucleus.mitochondria78.10.94No -
C’ GFP library in Starvation Media

nucleus,mitochondria82.180.99No -
C’ GFP library on the background of Pup2-DaMP

nucleus:mitochondria -
C’ GFP library on the background of CCT mutant

nucleus:mitochondria72.76680.877683No
